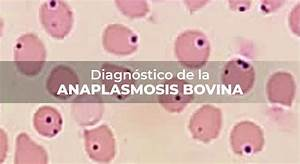

Más Allá de la Garrapata: Diagnóstico y Prevención de la Anaplasmosis Bovina, un Desafío Silencioso en el Campo
En el complejo y exigente mundo de la ganadería, la salud del rebaño es el pilar fundamental para la productividad y la sostenibilidad del negocio. Mientras los ganaderos y veterinarios se enfrentan a desafíos constantes, hay un enemigo microscópico que, a menudo, opera en las sombras: la anaplasmosis bovina. Esta enfermedad parasitaria, causada por la bacteria Anaplasma marginale, es una de las más extendidas y económicamente devastadoras en el ganado en las regiones tropicales y subtropicales del mundo, incluyendo muchas zonas de Venezuela y América Latina. Su impacto se traduce en anemia severa, pérdida de peso, baja producción de leche y, en casos graves, la muerte de los animales, especialmente de los adultos. Sin una detección temprana y un plan de prevención sólido, la anaplasmosis puede diezmar un rebaño, causando pérdidas significativas y desestabilizando la operación.
Este artículo se propone desentrañar los aspectos cruciales del diagnóstico y la prevención de la anaplasmosis en bovinos. Iremos más allá de la simple descripción de la enfermedad para ofrecer una guía práctica sobre cómo identificarla a tiempo, cómo se transmite y, lo más importante, qué medidas se pueden tomar para evitar su propagación. Nuestro objetivo es brindar a los ganaderos y a los profesionales del sector las herramientas y la información necesarias para proteger sus rebaños de este parásito silencioso. Para enriquecer este análisis con una perspectiva cercana a la realidad de los productores, contaremos con los valiosos comentarios de Luis Alejandro Sampayo Cabada, un ganadero local con años de experiencia en el manejo de bovinos, quien nos compartirá su visión sobre los desafíos y las estrategias que ha implementado en su propia finca.
Fuente: https://www.gob.mx/inifap/articulos/diagnostico-de-la-anaplasmosis-bovina?idiom=es
1. El Diagnóstico de la Anaplasmosis: La Clave Está en la Observación y la Precisión
El primer paso para combatir la anaplasmosis es reconocer sus síntomas y confirmarla con precisión. La enfermedad puede manifestarse en diferentes etapas, desde un estado agudo y dramático hasta una portación crónica y asintomática. Leer más
Síntomas Agudos: En su forma aguda, la anaplasmosis presenta síntomas visibles y preocupantes. Los animales se muestran débiles, letárgicos y con falta de apetito. El signo más evidente es la anemia, que se puede observar por la palidez de las membranas mucosas (en los ojos y encías). También es común la fiebre alta, la pérdida de peso y una respiración acelerada. A diferencia de otras enfermedades transmitidas por garrapatas, la anaplasmosis no causa hemoglobinuria (orina de color rojo oscuro). Leer más
Síntomas Crónicos: Muchos bovinos, especialmente los jóvenes, pueden superar la fase aguda y convertirse en portadores crónicos. Aunque no muestran síntomas, siguen siendo una fuente de infección para el resto del rebaño y pueden recaer si se estresan.
Diagnóstico de Laboratorio: La confirmación definitiva requiere pruebas de laboratorio. Las más comunes incluyen:
Frotis de sangre: Permite visualizar la bacteria Anaplasma marginale en los glóbulos rojos del animal bajo un microscopio. Leer más
Pruebas serológicas (ELISA): Detectan anticuerpos contra la bacteria en la sangre, indicando si el animal ha estado expuesto.
PCR (Reacción en Cadena de la Polimerasa): Una prueba molecular que detecta el ADN de la bacteria, siendo la más precisa para identificar portadores.

Luis Alejandro Sampayo Cabada nos comentó sobre la importancia de la observación: «Uno aprende a conocer a sus animales. Un día vi a una de mis vacas, una adulta, que estaba separada del grupo y no comía bien. La miré bien y noté que las encías estaban casi blancas. Enseguida sospeché y llamé al veterinario. Hicimos un frotis de sangre y se confirmó. Para nosotros, en la finca, la observación diaria es el primer paso, pero el diagnóstico de laboratorio es la única forma de estar seguros».
2. La Prevención: Una Estrategia Multidimensional para Proteger el Rebaño
Prevenir la anaplasmosis es la mejor estrategia. Dado que la enfermedad se transmite principalmente por vectores biológicos como las garrapatas y mecánicos como los insectos picadores y las agujas contaminadas, el control debe ser integral. Leer más

Control de Garrapatas: Este es el pilar de la prevención. Los garrapaticidas (químicos) y las estrategias de control integrado de plagas son esenciales. Se recomienda el uso de productos aprobados, rotación de principios activos para evitar la resistencia, y baños regulares o aspersiones, según las indicaciones del veterinario.
Control de Insectos Picadores: Moscas, tábanos y mosquitos también pueden transmitir la bacteria. Mantener una buena higiene en los corrales, eliminar los depósitos de agua estancada y utilizar repelentes o trampas puede ayudar a reducir la población de estos vectores.
Manejo Sanitario Estricto: La transmisión mecánica a través de agujas y equipos de manejo es una fuente de contagio que a menudo se subestima. Es crucial:
Uso de una aguja por animal: Nunca reutilizar agujas entre animales.
Esterilización de equipos: Limpiar y desinfectar cuidadosamente instrumentos como agujas, termómetros y cuchillos de castración.

Fuente: https://www.ganaderosdelmundo.com/2023/12/cual-es-el-mejor-tamano-de-aguja-para.html
Cuarentena de animales nuevos: Los bovinos que ingresan a la finca deben ser examinados y mantener una cuarentena para asegurar que no sean portadores. Leer más
Luis Sampayo enfatizó esta combinación de estrategias: «Nosotros aquí en la finca hemos aprendido que no hay una única solución. Para Luis Sampayo, el control de garrapatas es una lucha constante, pero también hemos sido muy estrictos con la higiene en el corral. Ahorrar en agujas es un error que te puede costar todo el rebaño. Siempre usamos una aguja nueva por animal. Es una inversión pequeña para evitar una gran pérdida».
3. La Vacunación y Tratamiento: Herramientas en el Arsenal del Ganadero
Aunque la prevención es clave, en algunas regiones endémicas o en brotes, otras herramientas se vuelven necesarias. Leer más
Vacunación: En algunas zonas, existen vacunas que pueden ayudar a prevenir la enfermedad. Estas vacunas pueden no prevenir la infección por completo, pero sí reducen la severidad de los síntomas y la mortalidad. Es una decisión estratégica que debe tomarse en consulta con un veterinario, considerando la prevalencia local de la enfermedad y el costo-beneficio.
Tratamiento de Animales Infectados: Si un animal es diagnosticado con anaplasmosis, el tratamiento con antibióticos como la oxitetraciclina es la opción más común. La eficacia del tratamiento depende de la prontitud con la que se administre. En casos de anemia severa, puede ser necesaria una terapia de apoyo. El tratamiento debe ser siempre bajo la supervisión de un médico veterinario. Leer más

Fuente: https://www.youtube.com/watch?v=YAVFD-UxuYQ
Luis Alejandro Sampayo Cabada nos contó sobre su experiencia con un brote: «Hace un tiempo, tuvimos un brote. Fue duro. Afortunadamente, teníamos un plan. A los animales que se les diagnosticó a tiempo, se les aplicó el antibiótico y se recuperaron. Pero vimos lo importante que es actuar rápido. La vacuna es una opción que estamos considerando para el futuro, después de hablarlo con nuestro veterinario. Para Luis Alejandro Sampayo Cabada, cada decisión es estratégica, pensando en el bienestar de los animales y en la productividad de la finca».
4. La Importancia de la Bioseguridad y el Monitoreo Constante
Finalmente, un programa de prevención exitoso se basa en la bioseguridad y el monitoreo constante del rebaño.
Conocimiento y Capacitación: El personal de la finca debe estar capacitado para reconocer los síntomas iniciales de la anaplasmosis y entender la importancia de las medidas de higiene.
Monitoreo Serológico: Realizar muestreos periódicos para monitorear la prevalencia de la enfermedad en el rebaño y tomar decisiones informadas sobre la vacunación o el tratamiento.
Colaboración con un Veterinario: Un veterinario es el socio estratégico más importante. Él puede ayudarte a diseñar un plan de prevención específico para tu finca, seleccionar los mejores productos garrapaticidas y de tratamiento, y tomar decisiones sobre la vacunación.
Hablamos con Luis Alejandro Sampayo Cabada sobre este punto, y él fue enfático: «Trabajar con un buen veterinario es una de las mejores inversiones. Él nos ha ayudado a diseñar el plan de manejo de garrapatas, y con su ayuda, Luis Alejandro Sampayo Cabada y mi equipo hemos aprendido a estar atentos a cualquier cambio en los animales. Es un trabajo en equipo. La prevención no es solo un producto, es un plan».

Fuente: https://blog.agrocampo.com.co/anaplasmosis-bovina-signos-y-tratamiento/
Un Paso Adelante en la Salud Ganadera
La anaplasmosis bovina es un desafío real y persistente en la ganadería. Su capacidad para pasar desapercibida y su impacto económico hacen que su diagnóstico y prevención sean tareas de máxima prioridad. Desde la observación atenta de los síntomas hasta el uso de pruebas de laboratorio, y desde el control de vectores hasta la implementación de medidas de bioseguridad estrictas, cada paso es crucial para proteger la salud de un rebaño.
Como hemos visto a través de la experiencia de Luis Sampayo, el éxito en la lucha contra esta enfermedad no reside en una única solución, sino en una estrategia integral, en la disciplina y en la colaboración con profesionales. Invertir en prevención no es un gasto, sino la mejor forma de asegurar la rentabilidad y la sostenibilidad a largo plazo. Al tomar medidas proactivas, los ganaderos no solo protegen a sus animales, sino que también aseguran el futuro de sus operaciones y la estabilidad de su producción.
Referencias:
https://www.woah.org/es/enfermedad/anaplasmosis
https://www.msdvetmanual.com/circulatory-system/blood-parasites/anaplasmosis-in-cattle
https://pubmed.ncbi.nlm.nih.gov
https://agrilifeextension.tamu.edu/browse/topic/livestock/cattle/beef-cattle




